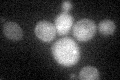
YGR142W
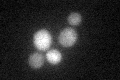
YGR142W
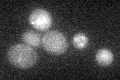
YGR142W

View description
v-SNARE binding protein that facilitates specific protein retrieval from a late endosome to the Golgi; modulates arginine uptake, possible role in mediating pH homeostasis between the vacuole and plasma membrane H(+)-ATPase
Localization:
Intensity:
Fold change:
Significance:
-
C’ GFP library in SD
cytosol25.77 -
N' NOP1pr-GFP in SD

punctate,nucleus64.4906 -
N' TEF2pr-mCherry in SD

punctate,nucleus54.4488 -
N' NATIVEpr-GFP in SD

punctate,nucleus35.525 -
N' TEF2pr-VC and Cyto-VN in SD

below threshold24.1778 -
C’ GFP library in SD+DTT
cytosol18.530.71No -
C’ GFP library in SD+H2O2

cytosol26.991.04No -
C’ GFP library in Starvation Media
cytosol28.151.09No -
C’ GFP library on the background of Pup2-DaMP

cytosol -
C’ GFP library on the background of CCT mutant

cytosol30.31651.17617No
